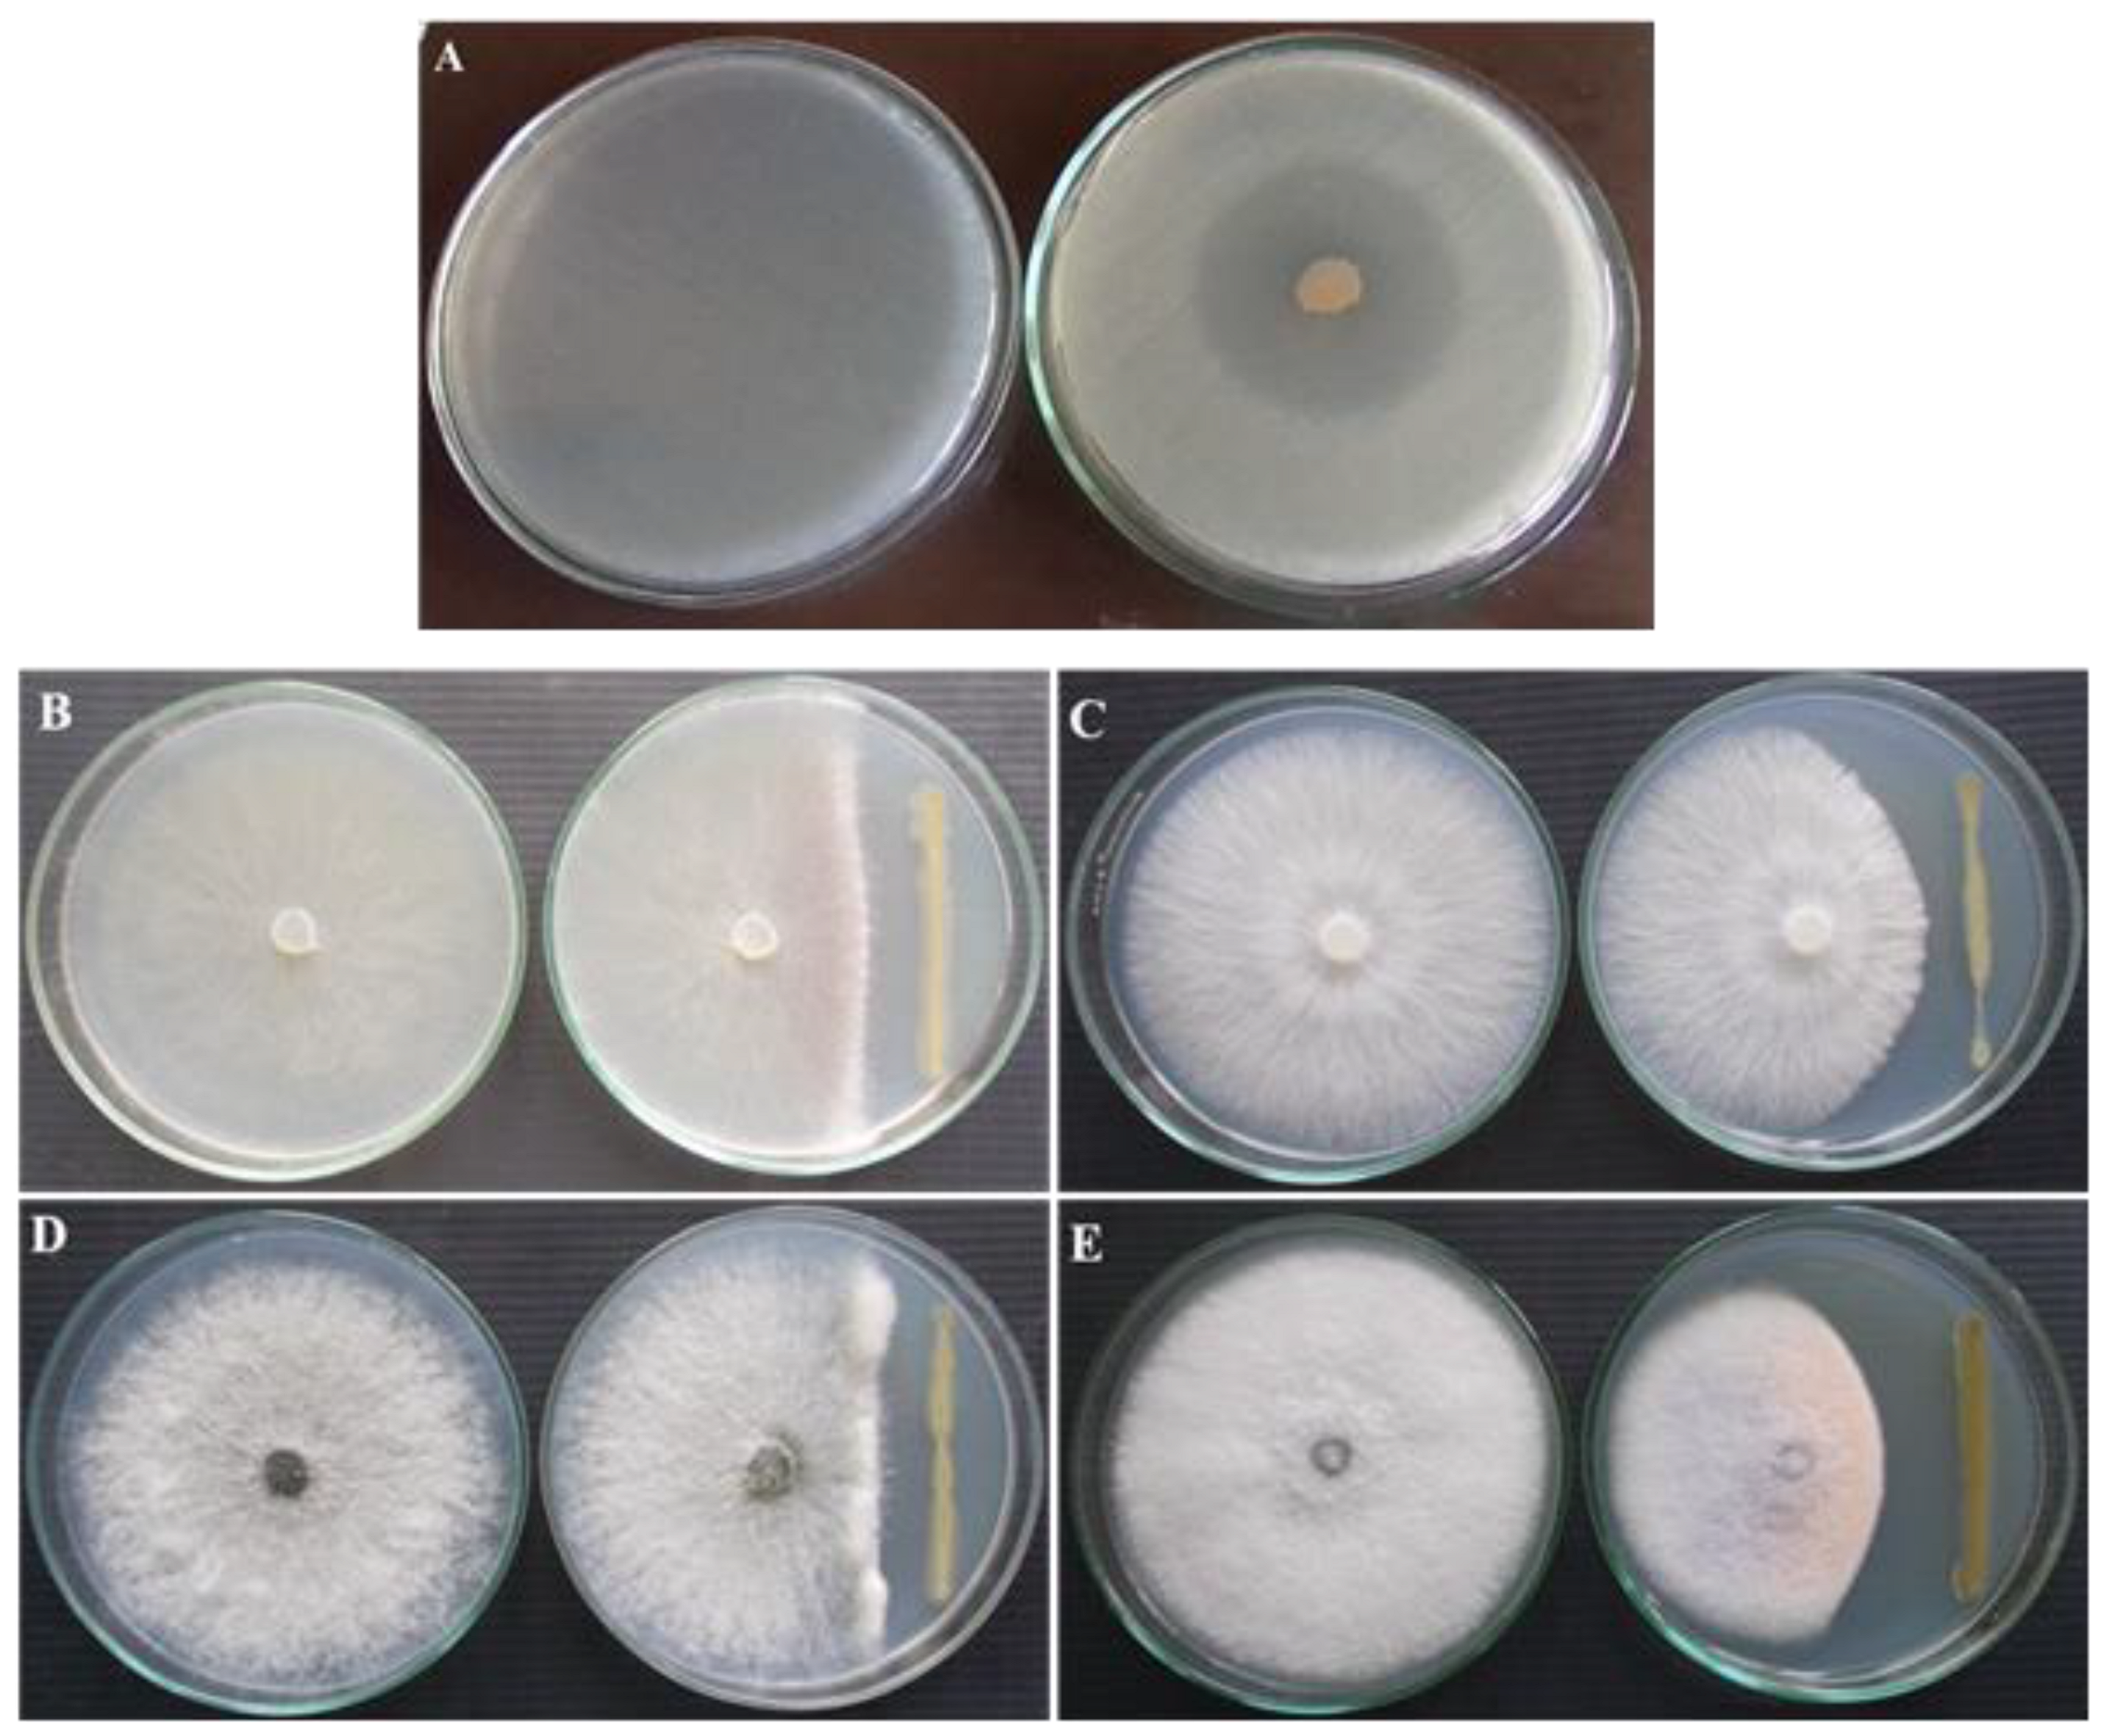
Microorganisms 10 01508 g001
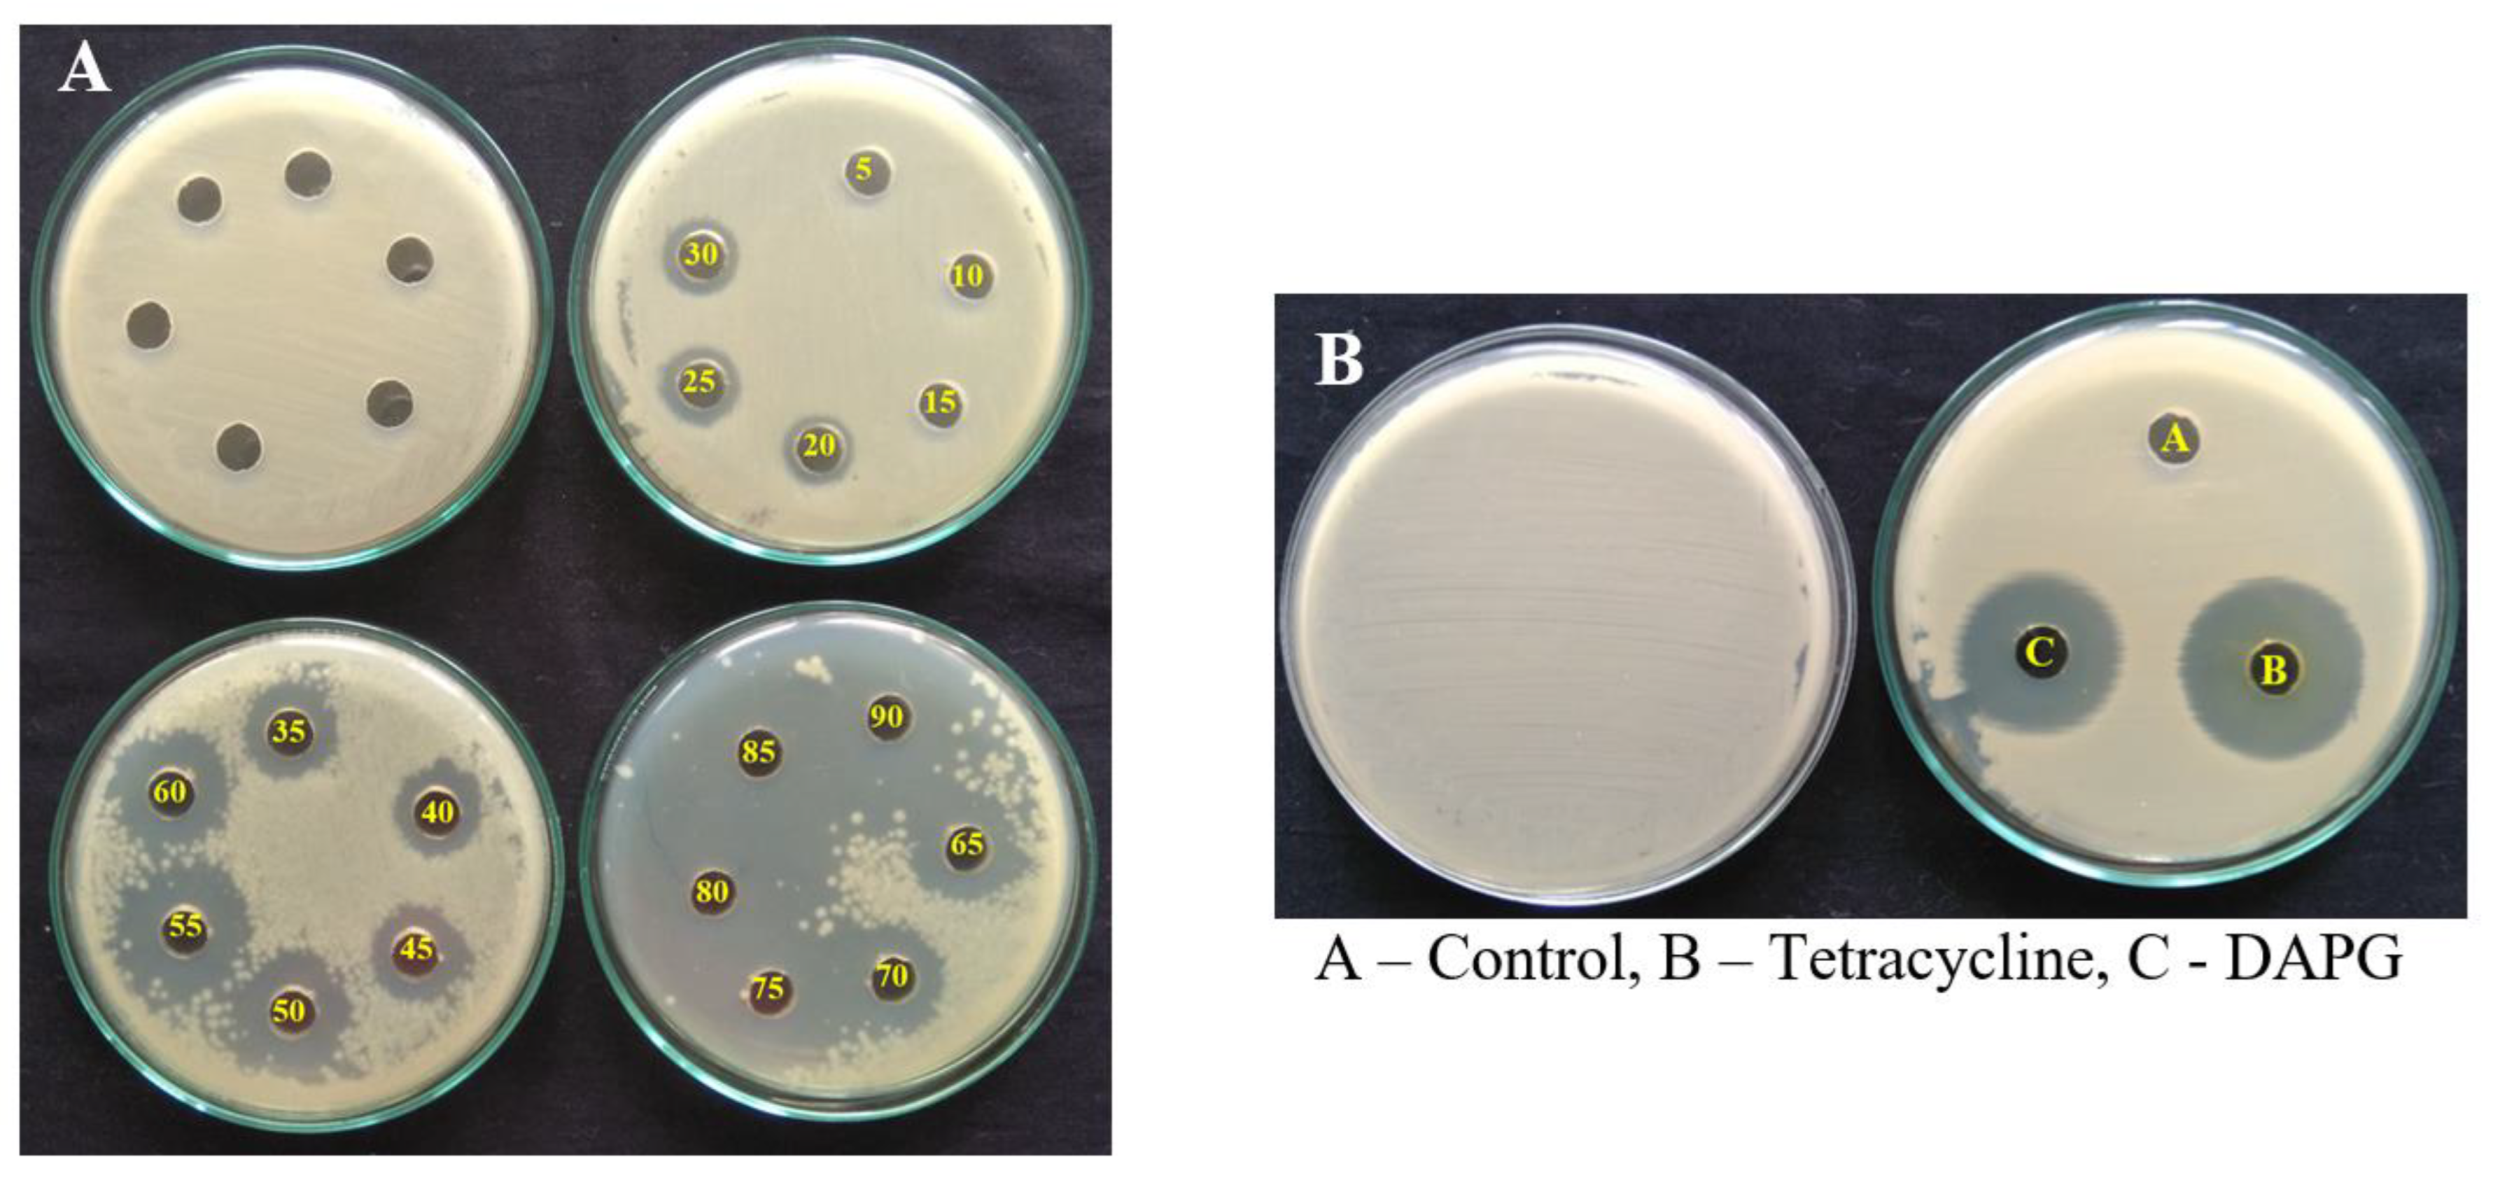
Microorganisms 10 01508 g006

Abstract
Microbial bio-products are becoming an appealing and viable alternative to chemical pesticides for effective management of crop diseases. These bio-products are known to have potential to minimize agrochemical applications without losing crop yield and also restore soil fertility and productivity. In this study, the inhibitory efficacy of 2,4-diacetylphloroglucinol (DAPG) produced by Pseudomonas fluorescens VSMKU3054 against Ralstonia solanacearum was assessed. Biochemical and functional characterization study revealed that P. fluorescens produced hydrogen cyanide (HCN), siderophore, indole acetic acid (IAA) and hydrolytic enzymes such as amylase, protease, cellulase and chitinase, and had the ability to solubilize phosphate. The presence of the key antimicrobial encoding gene in the biosynthesis of 2,4-diacetylphloroglucinol (DAPG) was identified by PCR. The maximum growth and antimicrobial activity of P. fluorescens was observed in king’s B medium at pH 7, 37 °C and 36 h of growth. Glucose and tryptone were found to be the most suitable carbon and nitrogen sources, respectively. DAPG was separated by silica column chromatography and identified by various methods such as UV-Vis, FT-IR, GC-MS and NMR spectroscopy. When R. solanacearum cells were exposed to DAPG at 90 µg/mL, the cell viability was decreased, reactive oxygen species (ROS) were increased and chromosomal DNA was damaged. Application of P. fluorescens and DAPG significantly reduced the bacterial wilt incidence. In addition, P. fluorescens was also found effective in promoting the growth of tomato seedlings. It is concluded that the indigenous isolate P. fluorescens VSMKU3054 could be used as a suitable biocontrol agent against bacterial wilt disease of tomato.
1. Introduction
Ralstonia solanacearum is a soil-borne plant pathogenic bacterium causing bacterial wilt disease in several crops, including tomato, worldwide and causing heavy economic loss [1]. Tomato bacterial wilt disease brings about nearly 60 to 100% crop loss [2,3]. The pathogen infects host plants by entering through natural wounds; it colonizes xylem tissues and blocks water channels in the xylem tissues, which results in a reduction in the supply of nutrients and water, leading to wilting in plants; finally, the host plant dies [4,5]. Its potent surviving capacity in various environments and wide host range make R. solanacearum very difficult to control using chemical pesticides [6]. Recent usage of chemical fertilizers and pesticides are hazardous to human and natural ecosystems. Thus, there is a need to find alternative methods in suppression of soil-borne phytopathogens to avoid the pollutants [7]. Thus, the application of potent anti-microbial agents producing strong inhibitory compounds is a promising alternative strategy.
Plant disease can be managed by biological control agents, especially P. fluorescens isolates, which efficiently control several bacterial and fungal plant diseases [8]. Garrido-Sanz et al. [9] demonstrated that the genus Pseudomonas includes 50 valid species and P. fluorescens is the most important bacterial species within the Pseudomonas group. P. fluorescens strains have been isolated from rhizosphere soil and shown to promote plant development. Hence, they are classified as plant growth promoting rhizobacteria (PGPR) [10,11]. They show direct and indirect mechanisms in suppression of plant pathogens and plant growth promoting activities [12,13,14,15]. Among the various mechanisms, the production of antimicrobial secondary metabolites such as phenazine, 2,4-diacetylphloroglucinol (2,4-DAPG), pyrrolnitrin, pyoluteorin, hydrogen cyanide and other metabolites is effective for the inhibition of soil-borne pathogens [16,17,18]. Among these metabolites, 2,4-DAPG is one of the most significant metabolites produced by P. fluorescens and it inhibits a broad spectrum of fungal and bacterial pathogens, including R. solanacearum [19,20,21]. It possesses anti-viral, antihelmintic and herbicidal activity along with other properties such as anti-lung, anti-leukemic and anti-breast cancer activity [22,23,24]. DAPG-producing P. fluorescens showed inhibitory effect against bacterial wilt in tomato. It significantly controlled bacterial wilt disease incidence under greenhouse conditions [21]. Several Pseudomonas species successfully control bacterial wilt disease caused by R. solanacearum in both in vitro and in vivo conditions [3,25,26,27]. Kwak et al. [28] reported the modes of action of DAPG, such as cleavage of the bacterial cell membrane, increasing ROS and DNA damage and finally leading to cell death. In this context, P. fluorescens and DAPG play a major role in controlling the bacterial wilt disease and increases the agricultural crop yield.
Keeping the importance of DAPG-producing P. fluorescens in suppression of various phytopathogens, the present study was carried out to characterize and assess the antagonistic activity and biocontrol efficacy of DAPG and DAPG-producing P. fluorescens VSMKU3054 against R. solanacearum and for the management of bacterial wilt in tomato.
2. Methods and Materials
2.1. Dual Culture Method
Antagonistic bacteria were isolated from tomato rhizosphere in Madurai district, Tamil Nadu, India. The antagonistic activity of P. fluorescens VSMKU3054 strain was tested against R. solanacearum and fungal phytopathogens viz. Rhizoctonia solani, Sclerotium rolfsii, Macrophomina phaseolina and Fusarium oxysporum by the dual culture plate technique. A dual culture plate assay was used to assess the antagonistic activity of P. fluorescens VSMKU3054 against R. solanacearum [29]. R. solanacearum (108 CFU/mL) was seeded on nutrient agar (NA) medium (Adding bacterial culture to the medium and plating) and a loopful of P. fluorescens VSMKU3054 was center-point inoculated. After two days of incubation at 30 °C, the zone of inhibition was measured to determine antagonistic activity. Potato dextrose agar medium (PDA) (Himedia Laboratories, Mumbai, India) was used for the dual culture plate technique for testing antagonistic activity of P. fluorescens VSMKU3054 against fungal pathogens. The bacterial colony was streaked on one side of the Petri plate and the fungal disk was placed on the center of the plate. PDA plates inoculated with pathogen alone served as the control. Antagonistic activities were evaluated by measuring the inhibition zones after 2–7 days of incubation at 28 °C (when the pathogen covered the entire plate in the control treatment).
2.2. Assessing Carbohydrate Utilization and Hydrolytic Enzyme Production
The selected isolate VSMKU3054 was identified as P. fluorescens VSMKU3054 by 16S rDNA sequence analysis in our previous study [30]. The carbohydrate fermentation was tested using the Hicarbo™ kit (KB009) as described by Himedia Laboratories, Mumbai, India.
Protease production by the isolate VSMKU3054 was determined on skim milk agar. Similarly, amylase, gelatinase, cellulase and chitinase production by the isolate VSMKU3054 were determined on nutrient agar with respective substrates [31,32]. All the hydrolytic enzyme activities were identified by colour change or a clear zone formation around the colony.
2.3. Production of Antimicrobial Metabolites by VSMKU3054
Siderophore production by P. fluorescens VSMKU3054 was assessed by chrome azurol S (CAS) agar method [33]. A loopful of P. fluorescens was streaked onto CAS agar medium and three days after incubation at 30 °C, siderophore production was observed by a change of colour from blue to brownish orange in the medium.
One millilitre of P. fluorescens colony was streaked on King’s B plates and Whatman filter paper soaked in a solution containing 0.5% picric acid and 2% sodium carbonate was placed in the lid plate. The cultures were incubated for two to three days for the production of HCN. The colour change from yellow to brick red indicates HCN production [34].
A single colony of P. fluorescens VSMKU3054 was streaked on Pikovskaya’s agar medium for the production of phosphate solubilisation [35]. Three days after incubation at 30 °C, the clear zone was observed around the colony. Production of IAA by P. fluorescens VSMKU3054 was tested with slight modification [36]. P. fluorescens VSMKU3054 was inoculated with 0.4% L-tryptophan supplementation on King’s B broth and incubated for 24 h. The 2 mL of cell-free culture filtrate was mixed with 4 mL of Salkowski reagent after centrifugation at 10,000 rpm for 15 min (1 mL of 0.5 M FeCl3 in 50 mL of 35 percent perchloric acid). The mixture was incubated for 20 min in dark conditions at room temperature and the colour change was observed.
2.4. Detection of 2,4-DAPG Antimicrobial Encoding Genes in P. fluorescens by PCR
Detection of DAPG-encoding gene phlD (2,4-diacetylphloroglucinol) was performed by using gene specific primers viz., B2BF (5′-ACCCACCGCAGCATCGTTTATGAGC-3′) and BPR4 (5′-CCGGTATGGAAGATGAAAAAGTC-3′) [37]. The PCR reaction resulted in a 629-bp amplicon for DAPG. P. fluorescens CHAO was used as a positive control. PCR amplification was carried out (Smart PCR, Cyber Lab, Somerset, NJ, USA) with 25 µL reaction mixture containing DNA 30 ng, 10× PCR buffer, 10 μM dNTP’s, 10 pmol of forward and reverse primer and 1U of Taq DNA polymerase (GeNeT Bio, Nonsan, Korea). The PCR program consisted of an initial denaturation at 95 °C for 3 min, followed by 30 cycles at 94 °C for 60 s, 57.5 °C for 60 s, 72 °C for 60 s, and a final extension at 72 °C for 5 min. The amplified products were separated on 1% agarose gel (Seakem Lonza, Rockland, ME, USA) in 1× TBE buffer (Himedia Laboratories, Mumbai, India). Bands were visualized by ethidium bromide staining and viewed under a gel documentation system.
2.5. Optimizing Growth Conditions for the Production of Antimicrobial Metabolites by P. fluorescens VSMKU3054
Five culture media viz. nutrient broth (NB), King’s B medium (KBB), Luria–Bertani (LB), Tryptone soya broth (TSB) and nutrient sucrose broth (NSB) (Himedia Laboratories, Mumbai, India) were used for evaluating the production of secondary metabolites by P. fluorescens VSMKU3054. All the media were sterilized and inoculated with P. fluorescens and incubated for 24 h at 37 °C. The cultures were centrifuged at 10,000 rpm for 10 min. LB medium was seeded with R. solanacearum and poured on Petri dishes. Wells were formed in LB medium. Culture filtrates of various media were applied in the agar well. The inhibitory effect of culture filtrate of P. fluorescens against R. solanacearum was assessed by measuring the inhibition zone [23,38]. To assess the effect of temperature on antimicrobial metabolite production, P. fluorescens VSMKU3054 was inoculated in King’s B broth and grown at different temperatures from 20, 25, 28, 31, 34, 37 and 40 °C for 24 h in a shaker at 120 rpm. After incubation, the inhibitory effect of cell-free culture filtrate against R. solanacearum was assessed on LB agar medium by measuring the inhibition zone as explained above [23]. To evaluate the effect of pH conditions on the production of antifungal metabolites, King’s B medium was prepared with different pH levels from 4 to 10 by adjusting with 0.1 N NaOH or 0.1 N HCl (Himedia Laboratories, Mumbai, India). The medium was inoculated with P. fluorescens VSMKU3054 and incubated for 24 h in a shaker at 120 rpm at 37 °C. The inhibitory effect of cell-free culture filtrate activity against R. solanacearum was examined as described above [23].
To evaluate the effect of various carbon sources on the production of antifungal metabolites, King’s B medium was prepared with various carbon sources (glucose, glycerol, fructose, cellulose, sorbitol, sucrose, starch, arabinose, lactose and xylose) amended at a concentration of 1% for the production of antimicrobial secondary metabolites. To determine the effect of various nitrogen sources for the production of antimicrobial secondary metabolites, King’s B medium was prepared with various nitrogen sources viz., beef extract, potassium nitrate, arginine, ammonium sulphate, ammonium nitrate, ammonium chloride, urea, yeast extract, tryptone and sodium nitrate at concentrations of 1% and inoculated with P. fluorescens and incubated for 24 h. Inhibitory activity of cell-free culture filtrate against R. solanacearum was evaluated as described above. The various growth periods (incubation time) were evaluated for the production of metabolites with different time intervals by culturing P. fluorescens in King’s B medium incubated for 96 h. Production of metabolites was evaluated at every 12 h interval and the inhibitory activity was tested against R. solanacearum as described above.
2.6. Mass Production and Extraction of DAPG
The optimized condition was applied for DAPG production. A total of 7 L of bacterial culture medium was used for production of metabolites. For extraction of metabolites, culture supernatant was mixed with an equivalent volume of ethyl acetate in a separating funnel and extracts were dried using a rotary vacuum evaporator.
2.7. Purification and Characterization of Metabolites
Extracted crude metabolites were fractionated using a column chromatographic technique to separate antimicrobial compounds. The glass column was used for separation and the size of the column was 25 cm height × 2 cm diameter. The column was thoroughly washed thrice with acetone solvent and dried. The glass column was sealed with non-absorbent cotton. Further, the metabolites were dissolved in ethyl acetate and mixed with silica gel (mesh size 60–120) to make a slurry preparation and air-dried. The column was tightly packed with silica gel and slurry was added then filled with sufficient ethyl acetate to avoid the column drying. The mixture of solvent systems was hexane: ethyl acetate with different ratios used for the purification process. Different ratios of solvents started from 100:0, 99:1, 98:2 up to 0:100%. The column was run and fractions were collected. Each fraction was run on TLC and visualized in a UV chamber; then, the same fraction was mixed in a single tube. A total of 126 fractions were collected and all the fractions were subjected to TLC.
Metabolites were separated on TLC silica gel plates (20 cm × 20 cm, aluminum oxide 60 F254, Merck, Darmstadt, Germany) using the solvent chloroform: methanol (9:1) [29] along with standard phloroglucinol (Sigma, Kawasaki, Japan) and Rf value was calculated. Then, 2,4-DAPG was analyzed using a UV-vis spectrophotometer with an absorbance range between 200 and 400 nm. An FT-IR spectrum was recorded for 400–4000 cm−1 and the crude sample was mixed with KBr (Shimadzu, Kyoto, Japan). Further, purified DAPG and standard DAPG were analysed using GC-MS. Conversion and selectivity were measured by an Agilent 7820A GC using an HP-5 column of 30 mm length and high pure nitrogen (99.999%) as the carrier gas with an FID detector. The initial oven temperature was fixed at 50 °C and the temperature was gradually increased up to 280 °C at a rate of 10 °C/min. The observed products in the final reaction mixture were confirmed with a 5890A model of the Agilent GC-MS instrument using an HP-5 column with 30 mm length and high pure helium (99.99%) gas as the carrier gas. Finally, DAPG was analysed by nuclear magnetic resonance (NMR). The 1H NMR and 13C NMR spectra were recorded on a Bruker Avance spectrometer using acetonitrile-d3 as solvent. 1H NMR was measured at 300 MHz and 13C NMR was measured at 128 MHz with chemical shifts (δ) expressed as values in parts per million (ppm). The splitting patterns in 1H NMR spectra are reported as follows: s = singlet; d = doublet; br s = broad singlet; m = multiplet. NMR (1H & 13C NMR) analyses for identifying the structure were drawn by Chemdraw software for the prediction of structure.
2.8. Assay of Minimum Inhibitory Concentrations (MIC) of DAPG and Its Effect on Cell Viability
The inhibitory effect of DAPG compounds was tested towards R. solanacearum in different concentrations (5–120 µg/mL). Live/dead assay of R. solanacearum against the pure compounds was performed by high content screening (HCS). DAPG at 90 µg/mL and tetracycline at 90 µg/mL were used as a positive control. Treated R. solanacearum was incubated for 8 h. After incubation, the cells were stained with acridine orange for live cells and propidium iodide for dead cell imaging [39]. The treated cells were analysed using the HCS imaging technique on a Perkin Elmer Operetta at 40× magnification and the image analysis was done using Harmony 3.0 software. Live cell percentage was calculated according to Yang et al. [40] with some modifications.
Percentage of live cell = Total No. of cell (green & red) − No. of dead cell (red)/Total No. of cell (green & red) × 100
2.9. Determination of Reactive Oxygen Species (ROS)
The bacterial intracellular ROS formation was detected by cell-permeable fluorescent dye 2,7-dichlorofluorescein diacetate (DCFDA), which has a fluorescence wavelength of emission at 523 nm and excitation at 503 nm [41,42]. R. solanacearum was grown overnight and treated with DAPG at MIC (90 µg/mL) concentration. Further, it was incubated for 6 h. After incubation, R. solanacearum cells were centrifuged for 15 min at 4000 rpm and the pellet was resuspended with PBS. Harvested bacterial cells were washed three times and 10 mM of DCFDA was added. Further, cells were incubated for 20 min in dark. Then excess dye was removed by using PBS wash. Finally, the cells were analysed immediately with an HCS imaging technique at 40× magnification Perkin Elmer Operetta and the image analysis was done using Harmony 3.0 software. At the same time, the ROS production was determined in tetracycline-treated R. solanacearum used as a positive control and untreated cells considered as a negative control.
2.10. DNA Damage of R. solanacearum
The DNA-damaging effect of purified DAPG on R. solanacearum DNA was assessed by agarose gel electrophoresis [42]. Three different treatments such as DAPG (90 µg/mL), tetracycline and control (without treatment) were carried out against R. solanacearum. After treatment, DNA was isolated from bacteria by manual methods and run on 0.8% agarose gel and visualized by gel documentation.
2.11. Efficiency of P. fluorescens on the Suppression of R. solanacearum under Greenhouse Experiment
2.11.1. Preparation of P. fluorescens and R. solanacearum
P. fluorescens VSMKU3054 was grown in KB medium for 24 h at 37 °C and the cells were centrifuged at 10,000 rpm for 10 min. After centrifugation, cells were washed with sterile phosphate buffer saline (PBS). Finally, they were resuspended in PBS. Further, bacterial cell suspensions were adjusted to 0.8 optical density at 600 nm (approximately 108 CFU/mL). The R. solanacearum was grown overnight in TSB medium and the bacterial culture was centrifuged at 10,000 rpm for 10 min. Further, the pellets were resuspended in PBS and the cell suspensions were adjusted to the 0.8 OD at 600 nm used for this study.
2.11.2. Preparation of Tomato Seedlings
PKM1 tomato seeds susceptible to bacterial wilt were obtained from the Horticultural College and Research Institute, Periyakulam, Tamil Nadu, India. A soil mixture consisting of soil: sand: vermicompost (2:1:1) was sterilized by autoclaving at 121 °C at 15 psi for 60 min. The potting soil mix was filled in clay pots (25 cm diameter; 8–10 kg capacity). The tomato seeds (PKM1) were surface sterilized using 1% sodium hypochlorite for 2 min and washed with sterile distilled water three times, then blot dried. Tomato seeds were grouped into three types such as control (sterile water), seeds treated with P. fluorescens culture and seeds treated with cell-free culture filtrate.
Thirty-day-old tomato seedlings (PKM1) were treated with P. fluorescens VSMKU3054 (108 CFU/mL) with the following treatments. In the soil drenching method, after transplantation, 20 mL of P. fluorescens suspensions was poured into each pot. In the root dipping method, tomato roots were soaked in suspensions of P. fluorescens VSMKU3054 for 20 min and transplanted into pots. For the seed treatment, tomato seeds were soaked with P. fluorescens VSMKU3054 and sown in the pots (25 seeds/pot); seedlings were transplanted into new pots after 30 days of sowing. In the foliar spray method, P. fluorescens (20 mL) was sprayed on 30 days after transplantation. Similarly, cell-free culture filtrate (20 mL) was sprayed on 30-day-old transplanted tomato seedlings. In all the treatments, two tomato seedlings were transplanted per pot. All the treatments were conducted with three replications. All the pots were placed in a greenhouse at 28 °C and 80% relative humidity [43,44]. The pot culture experiment was laid out in greenhouse conditions using a completely randomized design.
T1—Control (without treatments).
T2—R. solanacearum alone.
T3—Tetracycline + R. solanacearum.
T4—P. fluorescens VSMKU3054 culture.
T5—P. fluorescens VSMKU3054 culture filtrate only.
T6—2,4-Diacetylphloroglucinol (DAPG) + R. solanacearum (Foliar Spray).
2.11.3. Soil Application (SA)
T7—P. fluorescens VSMKU3054 culture + R. solanacearum.
T8—P. fluorescens VSMKU3054 culture filtrate + R. solanacearum.
2.11.4. Root Dipping (RD)
T9—P. fluorescens VSMKU3054 culture + R. solanacearum.
T10—P. fluorescens VSMKU3054 culture filtrate + R. solanacearum.
2.11.5. Seed Treatments (ST)
T11—P. fluorescens VSMKU3054 culture + R. solanacearum.
T12—P. fluorescens VSMKU3054 culture filtrate + R. solanacearum.
2.11.6. Foliar Spray (FS)
T13—P. fluorescens VSMKU3054 culture + R. solanacearum.
T14—P. fluorescens VSMKU3054 culture filtrate + R. solanacearum.
After 10 days of transplanting, the soil was drenched with 20 mL of R. solanacearum (108 CFU/mL) on the tomato root surface. In control, plants were treated with 20 mL of sterile water. In the positive control, 90 µg/mL (20 mL) of tetracycline was applied at the time of transplantation of tomato seedlings. Tomato plants were treated with DAPG at 90 µg/mL (20 mL). Afterward, the treated plants were monitored and disease incidence was observed and measured at 5–30 days. The disease incidence was recorded based on disease grade scale 0–4 with ranges: 0 = no wilting (healthy), 1 = 1–25%, 2 = 26–50%, 3 = 51–75% and 4 = 76–100% wilted or dead plant [43,45,46]. Finally, the biocontrol efficacy of P. fluorescens and compound were assessed. Fresh and dry weight and shoot and root lengths were measured at the 60th day. The biocontrol efficacy and disease incidence were also calculated.
Disease incidence = Sum of disease ratings/Total number of plants investigated × Highest disease index × 100%
Biocontrol efficacy = Disease incidence in control × Disease incidence in treatments/Disease incidence in control × 100%
2.12. Statistical Analysis
The greenhouse efficacy trial data were analysed using the analysis of variance (SAS Institute Inc., 1991, Cary, NC, USA). The data are mean values of three replicates ± standard deviation; means with different letters differ significantly at p = 0.05 according to Fisher’s LSD. The least significant difference (LSD) and Duncan’s Multiple Range Test (DMRT) were used to separate the treatment means.
3. Results
3.1. Antagonistic Activity of P. fluorescens VSMKU3054 against Plant Pathogens
The antimicrobial activity of P. fluorescens was investigated using a dual culture plate assay method against a variety of soil-borne plant pathogens. P. fluorescens exhibited 28.2 mm of inhibition zone against R. solanacearum; 24.57 mm against R. solani; 21.5 mm against S. rolfsii; 23.77 mm against M. phaseolina; and 27.13 mm against F. oxysporum (Table 1; Figure 1).
Table 1.
Antagonistic activity of P. fluorescens VSMKU3054 against R. solanacearum and fungal plant pathogens.
Figure 1.
Antagonistic activity of P. fluorescens VSMKU3054 against plant pathogens by dual culture plate assay. (A)—P. fluorescens + R. solanacearum, (B)—P. fluorescens +R. solani, (C)—P. fluorescens + S. rolfsii, (D)—P. fluorescens +M. phaseolina and (E)—P. fluorescens + F. oxysporum.
3.2. Phenotypic and Biochemical Characterization
The morphological identification of P. fluorescens VSMKU3054 under scanning electron microscopy (TESCAN VEGA3 SBH, Brno, Czech Republic) revealed that they are rod-shaped. It showed positive results for the catalase test, the oxidase test and the citrate utilization test, whereas the results were negative for the IMVIC test. Hicarbo test kit results showed that P. fluorescens utilized carbon sources such as lactose, galactose, maltose, fructose, trehalose, dextrose, melibiose, L-arabinose, glycerol, sucrose, mannose, mannitol, arabitol, D-arabinose, malonate and citrate, whereas it showed negative results for other carbon sources such as xylose, sorbitol, raffinose, inulin, sodium gluconate, salicin, inositol, dulcitol, alpha-methyl glucose, rhamnose, adonitol, melezitose, alpha-methyl D-mannose, cellobiose, ONPG, sarbose, xylitol and esulin.
3.3. Secondary Metabolites Produced from P. fluorescens VSMKU3054
P. fluorescens VSMKU3054 showed a positive result for hydrogen cyanide production, as revealed from colour change of the strip from yellow to brown (Figure 2C), and a positive result for siderophore production, as revealed from brown zone formation around the bacterial colony on CAS medium (Figure 2A). It also showed a positive result for phosphate solubilisation, as revealed from the formation of a clear zone around bacterial colonies (Figure 2D), and also produced the plant growth-promoting phytohormone indole acetic acid (Figure 2B).
Figure 2.
Secondary metabolites produced from P. fluorescens VSMKU3054. (A) siderophore, (B) indole acetic acid, (C) hydrogen cyanide & (D) phosphate solubilization.
3.4. Detection of DAPG Antibiotic Gene Amplification by PCR
P. fluorescens VSMKU3054 showed the presence of an antibiotic gene fragment for DAPG based on PCR analysis, as observed in P. fluorescens CHAO used as a positive control; the amplification of the DNA fragment was 629 bp. (Figure 3).
Figure 3.
Detection of DAPG encoding gene from P. fluorescens VSMKU3054. M-Marker (1 kb), 1—CHAO, 2—P. fluorescens.
3.5. Optimizing the Growth Conditions for Antimicrobial Metabolite Production by P. fluorescens
The biomass production of P. fluorescens increased in five different culture media. Among the culture media tested, King’s B broth showed the highest production of biomass followed by NB, TSB and NSB in 2 days of incubation. The antimicrobial metabolite production was the maximum in KB medium, as revealed from the highest inhibition zone of 23.4 mm at 100 µL of sample (Figure 4A). With regard to temperature conditions, the maximum antimicrobial metabolites production by P. fluorescens VSMKU3054 was observed when it was grown at 37 °C, as revealed from the highest inhibition zone (22.33 ± 1.52 mm). Minimum antimicrobial activity (3 mm inhibition zone) was observed when P. fluorescens was grown at 40 °C (Figure 4C). With regard to pH conditions, the highest antimicrobial activity (24 mm inhibition zone) was noticed when P. fluorescens was grown at pH 7; the lowest antimicrobial activity was recorded at pH 10. (Figure 4B).
The influence of diverse carbon sources on antibacterial compound synthesis was investigated. The best carbon source for the formation of antibacterial compounds was found to be glucose, followed by sucrose, starch, lactose, sorbitol, glycerol and fructose. The least antibacterial activity was noticed when xylose was used as a carbon source (Figure 4D). Among the various nitrogen sources tested, tryptone supplementation supported the maximum antimicrobial metabolite production by P. fluorescens VSMKU3054, followed by beef extract, L-arginine and yeast extract, whereas urea and ammonium nitrate showed the minimum antimicrobial compound production (Figure 4E).
Among the various growth periods tested, culturing P. fluorescens for a period of 36–48 h resulted in the maximum production of antimicrobial bioactive metabolites, followed by 24, 12 and 60 h. The minimum production of bioactive metabolites was recorded at 84–96 h (Figure 4F).


Figure 4.
Optimization of P. fluorescens VSMKU3054 biomass with various abiotic parameters. (A) Medium, (B) temperature, (C) pH, (D) carbon sources, (E) nitrogen sources and (F) time.
Figure 4.
Optimization of P. fluorescens VSMKU3054 biomass with various abiotic parameters. (A) Medium, (B) temperature, (C) pH, (D) carbon sources, (E) nitrogen sources and (F) time.



3.6. Extraction and Purification of Secondary Metabolites
Purification of antimicrobial compounds from crude metabolites was separated by a silica column chromatographic technique. A total of 126 fractions were collected using column chromatography and all the fractions were run into TLC. After TLC analysis, sample fractions with the same retention time spot were mixed and pooled in the same tube. A total of nine compounds were selected and among the nine compounds, one compound numbered as 7 that matched the Rf value of standard phloroglucinol was collected and purified; the total amount of purified compound was 184 mg.
3.7. Characterization of Purified Compound
The purified compound 7, separated by TLC, has an Rf value of 0.82 that corresponds with standard phloroglucinol (Figure 5A). The compound 7 was analysed by a UV–vis spectrophotometer between the wavelengths of 200–600 nm and absorption peaks were obtained at 270 nm (Figure 5B). The FT-IR analysis results showed the peaks of 3473.8, 2981.95, 1757.15, 1608.7, 1458.18, 1244.09, 1055.06 and 929.69/cm and the functional group present in the FT-IR spectrum indicated the presence of phenolic OH groups, methyl groups, aromatic rings, and C–H groups in C–CH3 and aryl carbonyl compounds, and C–OH in alcohols, ethers, acid esters stretching, respectively (Table 2 and Figure 5C). P. fluorescens VSMKU3054 purified compound identification by GC-MS analysis obtained a mass spectrum at 210.4 m/z; further, it fragmented at 191.2, 175.1 and 147.1 m/z with a retention time of 10.893 min corresponding to authentic DAPG for further confirmation (Figure 5D).
Table 2.
Functional groups of purified DAPG by FT-IR analysis.
1H and 13C NMR spectra were recorded on a 300 MHz Bruker NMR spectrometer using the solvent CD3CN. In 1H NMR.; diacetyl phloroglucinol peaks showed 2.63 singlet at 6H acetyl moiety (2 COCH3); 5.79 (singlet, 1H, Ar-H) aromatic proton of benzene ring and singlet 1.94 acetonitrile solvent peaks appeared; the assignments of the peaks are very well matched with compound structure (Figure 5E). 13C NMR spectra were recorded on 128 MHz using acetonitrile-d3 as solvent; peaks appeared (1.32 & 110.34 ppm), and the compound peaks showed 28.58 ppm (2 CH3), 95.47 ppm (Ar-H), 104.64 ppm (2 C-COCH3), 167.08 (Car-OH), 169.59 ppm (2 Car-OH) and 204.70 ppm (2 C=O) (Figure 5F).
The DAPG compound is visually observed as yellow in colour and soluble in ethyl acetate, chloroform, water, acetonitrile and methanol. The molecular formula of the DAPG antibiotic is C10H10O5 and molecular weight of the DAPG compound is 210 (Figure 5G).


Figure 5.
Characterization of 2,4-DAPG metabolites. (A) TLC; a: Authentic (Phloroglucinol). b: DAPG, (B) UV, (C) FT-IR, (D) GC-MS, (E) 1H, (F) 13C NMR and (G) structure of DAPG compound.
Figure 5.
Characterization of 2,4-DAPG metabolites. (A) TLC; a: Authentic (Phloroglucinol). b: DAPG, (B) UV, (C) FT-IR, (D) GC-MS, (E) 1H, (F) 13C NMR and (G) structure of DAPG compound.



3.8. Bioactive Assay of DAPG against R. solanacearum
The purified DAPG compound isolated from P. fluorescens VSMKU3054 was tested to find its minimum inhibitory concentration against R. solanacearum with varying concentrations ranging from 5–120 µg/mL. The results showed that 90 µg/mL concentration of DAPG significantly inhibited R. solanacearum and was considered as the lowest concentration showing a greater zone of inhibition of 19.03 ± 0.35 mm. DAPG at 15 µg/mL showed no inhibition and antibacterial activity started from 20 µg/mL, showing a zone of inhibition when compared to commercial antibiotic tetracycline (Table 3 and Figure 6).
Table 3.
Minimum inhibitory concentration of DAPG from P. fluorescens VSMKU3054 against R. solanacearum.
Figure 6.
MIC of DAPG compound against R. solanacearum. (A) Different concentrations of DAPG metabolites against R. solanacearum and (B) 90 µg/mL concentration of tetracycline and DAPG.
3.9. Live/Dead Cell Assay of R. solanacearum
Cells of R. solanacearum were treated with purified DAPG and they were observed under a high content screening imaging technique. Fluorescent dyes were used for visualizing intactness of cell membranes and nucleic acids. Cells with intact cell membranes showed green coloured cells, indicating live cells, and red coloured cells, considered as dead cells. Cells of R. solanacearum treated with DAPG showed a drastic reduction in viability compared to control. The DAPG treatment resulted in only 36% live cells and tetracycline (90 µg/mL) treatment resulted in 29% viable cells (Table 4; Figure 7).
Table 4.
Live/dead assay of R. solanacearum.
Figure 7.
Live/dead assay of R. solanacearum in high content screening imaging system. Green and red stained cells considered as live and dead cells, respectively. (A) R. solanacearum alone (Control), (B) R. solanacearum treated with tetracycline at 90 µg/mL and (C)—R. solanacearum treated with DAPG at 90 µg/mL. Scale bar: 20 µm.
3.10. Reactive Oxygen Species Assay—DAPG
A cell permeable assay was conducted by detection of ROS levels in R. solanacearum upon DAPG treatment using the fluorescent probe DCFDA. After treating R. solanacearum cells with DAPG, the generation of ROS accumulation in intracellular cell membranes was significantly increased, leading to cell membrane damage. The higher level of ROS accumulation was measured based on the increased intensity of the fluorescent probe that binds with both cell membranes and protein. Further, tetracycline treatment on R. solanacearum also significantly increased intensity of fluorescence bound to cell membranes and higher accumulation of ROS when compared to control. In control, there was no generation of ROS. The intracellular ROS accumulation was higher in tetracycline- than DAPG-treated cells (Figure 8).
Figure 8.
Accumulation of reactive oxygen species in R. solanacearum cells treated with DAPG at 90 µg/mL concentration at 6 h incubation time. Green fluorescence indicates the DCFDA dye binds with ROS accumulation in R. solanacearum cell membrane. (A) Control (untreated), (B) tetracycline and (C) DAPG. Scale bar: 20 µm.
3.11. DNA Damage Assay
DNA damage due to DAPG and tetracycline treatment of R. solanacearum was observed based on the intactness of total genomic DNA. Tetracycline-treated R. solanacearum caused damage and showed the low intensity of DNA, followed by DAPG-treated R. solanacearum cells, and DNA fragmentation was observed compared to control (Figure 9).
Figure 9.
Agarose gel electrophoresis analysis of genomic DNA in R. solanacearum treated with DAPG and tetracycline. Lane 1: control; 2: tetracycline; and 3: DAPG.
3.12. Biocontrol Efficiency of P. fluorescens VSMKU3054 and 2,4-DAPG against Tomato Bacterial Wilt Disease under Greenhouse Conditions
A total of 14 treatments were evaluated under greenhouse conditions along with control, and the efficacy of P. fluorescens VSMKU3054 and 2,4-DAPG against tomato bacterial wilt disease was assessed. Bacterial wilt common symptoms appeared in all the treatments challenge-inoculated with R. solanacearum from the fifth day’s post-inoculation (dpi). The observation of disease severity was calculated in all the treatments and the highest disease severity was observed in R. solanacearum-inoculated control plants (Figure 10).

Figure 10.
Biocontrol efficacy of P. fluorescens and 2,4-DAPG against bacterial wilt pathogen R. solanacearum in tomato plants under greenhouse conditions. (A) T1-control, T2-R. solanacearum alone, T3-Tetracycline, T4-P. fluorescens (Pf), T5-P. fluorescens culture filtrate (CF); (B) DAPG compound treated plants (T6); (C) soil application of Pf and CF (T7&T8); (D) root dipping method of Pf and CF (T9&T10); (E) seed treatments of Pf and CF (T11&T12); (F) foliar spray methods of Pf and CF (T13&T14) treated with tomato plants.
All the treatments successfully reduced the severity of bacterial wilt disease. Among the various treatments, application of P. fluorescens as soil-drenching recorded the lowest percentage of disease incidence (46.6%) The wilt symptoms were delayed when the plants were applied either with P. fluorescens or tetracycline antibiotic. Further P. fluorescens-inoculated plants showed significantly increased root and shoot lengths, fresh and dry weights, and biomass (Table 5). P. fluorescens VSMKU3054 was observed to be the most effective treatment for application when compared with other treatments.
Table 5.
Biocontrol efficiency of P. fluorescens VSMKU3054 and 2,4-DAPG against bacterial wilt disease in tomato (PKM1) growth under greenhouse conditions.
4. Discussion
In recent years, the utilization of microbes to improve plant growth and health has gained attention. Antibiotic production by soil saprophytic antagonistic organisms suppressed various phytopathogenic microbes in soil ecosystems [18,47]. Several methods have been developed to control bacterial wilt disease caused by R. solanacearum, including biological control, cultivation of resistant cultivators and soil organic amendments [48,49]. Biological control is one of the most prevalent and successful approaches for controlling plant diseases among these strategies. Several studies have documented that P. fluorescens is a significant biocontrol agent that suppresses soil-borne phytopathogens under invitro and in vivo conditions through direct or indirect mechanisms [3,10,11,50,51]. In the process of biological control, the selection of potential antagonistic microorganisms to suppress the growth of R. solanacearum and other soil-borne phytopathogens is considered as the first and foremost important step. Native isolates are more effective than exotic isolates in suppressing soil-borne diseases, according to numerous studies [25,52,53]. Previous studies have revealed that the selection of potential biocontrol agents was based on their antagonistic activity against R. solanacearum [49,54].
In this study, P. fluorescens VSMKU3054 showed the strongest antibacterial activity against R. solanacearum and antifungal activity against R. solani, S. rolfsii, M. phaseolina and F. oxysporum by significantly arresting mycelial growth with the production of antimicrobial metabolites. Similar to the results of the present study, earlier studies also reported that P. fluorescens strongly inhibited the growth of R. solanacearum by the production of different secondary metabolites [27,55]. Rai et al. [56] reported that Pseudomonas sp. strain RS-9 showed significant antagonistic activity against R. solanacearum and several fungal phytopathogens. P. fluorescens also showed strong antagonistic activity against fungal pathogens [36,57].
P. fluorescens produces potential antimicrobial compounds that are involved in enhancing plant growth promotion activity and also inhibition of plant diseases. In this study, P. fluorescens VSMKU3054 showed positive results for HCN, siderophore, phosphate solubilisation and IAA production. Furthermore, it produced lytic enzymes such as protease, amylase, chitinase, cellulose, pectinase and gelatinase, and improved plant growth as well as controlled plant disease. In accordance with the previous reports herein, Pseudomonas sp. produced antimicrobial compounds such as siderophore, HCN and hydrolytic enzymes that are implicated in fungal cell-wall degradation, reducing plant disease incidence and increasing plant growth promotion [44,52,58]. P. fluorescens VSMKU3054 harbours DAPG encoding gene fragments, which is confirmed by PCR analysis in accordance with the reports of Immanuel et al. [37].
Antibiotic production of fluorescent pseudomonas is affected by some abiotic factors such as carbon and nitrogen sources, temperature, pH and culture media [23,59,60]. Pseudomonas sp. produced 2,4-DAPG and culture conditions such as pH, temperature, and carbon and nitrogen sources influenced its total production [23,61]. Similarly, our study exhibited that metabolite production by P. fluorescens was influenced by abiotic factors for optimum growth. Accordingly, growth curve studies on various fluorescent pseudomonas indicated that maximum growth rate and lowest doubling time were observed in King’s B medium [62]. The present study also showed that the highest growth rate was noticed when P. fluorescens was cultured in King’s B medium.
Previous studies reported that fluorescent pseudomonas play an important role in producing antibiotics and thereby controlling phytopathogens [31,63]. DAPG possesses anti-helminthic, anti-viral and herbicidal activities, and it is also reported to be toxic against bacteria as well as fungi. P. brassicacearum J12 was identified with the 2,4-DAPG compound, which significantly inhibited R. solanacearum. DAPG shows broad-spectrum antimicrobial activity and it targets one or more cellular processes [23]. In our study, TLC, UV and FT-IR spectrophotometers confirmed that P. fluorescens VSMKU3054 produced the 2,4-DAPG compound, and the results were in accordance with previous reports of Ayyadurai et al., [64]. According to Brucker et al. [65] UV-visible spectrometer examination of DAPG revealed a peak of about 270 nm. In this investigation, GC-MS analysis revealed that the chromatogram peak of DAPG from P. fluorescens VSMKU3054 coincided with that obtained from standard DAPG [66,67]. Further confirmation of DAPG was done with 1H and 13C NMR and their structural elucidation of the compound was identified as DAPG, which coincided with previous literature data [66,67,68].
The antibacterial activity of various Pseudomonas sp. producing DAPG compounds was tested towards R. solanacearum and the results exhibited that the highest zone of inhibition was observed in isolate EC21 [25]. Nagendran et al. [69] reported that the effect of 2,4-DAPG produced by P. fluorescens TNAU PF1 strains towards the bacterial wilt pathogen R. solanacearum was tested by the agar well diffusion method, and the zone inhibition was observed to be 15.67 mm. In the present study, MIC was determined as 90 µg/mL against R. solanacearum. Live/dead assay (39%) of DAPG compounds produced by P. fluorescens VSMKU3054 strongly reduced the growth of R. solanacearum as compared to cells treated by tetracycline (29%) and untreated cells. The results of the present study were in accordance with the previous study, which showed that R. solanacearum had a lower number of live cells [39].
Oxygen is essential for all living organisms and it is also a precursor of ROS, due to damage caused to organelles such as nucleic acids, proteins and other components. ROS lead to the damage of cell membranes and increase lipid peroxidation, which can cause membrane leakage and deteriorating effects on the respiratory system, resulting in apoptosis [42,70,71]. In the present study, 2,4-DAPG treatment of R. solanacearum showed substantial DNA damage. Further, significant DNA fragmentation was observed at 90 µg/mL concentrations, which was concordant with the reports of Cai et al. [42] and Roy et al. [72].
The biocontrol efficiency of P. fluorescens VSMKU3054 significantly reduced wilt disease incidence in tomato plants caused by R. solanacearum compared to antibiotic control under in vivo conditions. Zhou et al. [21] previously reported that P. fluorescens having the phlF gene exhibited a higher zone of inhibition against R. solanacearum; further, 2,4-DAPG production was enhanced in phlF- mutant strains and superior colonization was observed in the rhizosphere, which might have effectively suppressed soil-borne pathogens. Furthermore, the wild-type J2 strain showed significant biocontrol efficacy against tomato bacterial wilt. The potential antagonistic bacterium P. protegens RS-9 strains could also produce 2,4-DAPG and successfully controlled bacterial wilt of tomato [56]. Recent studies showed that B. velezensis B63 and P. brassicacearum P142 isolates are promising biocontrol agents against bacterial wilt in tomato plants under field conditions due to the production of plant growth promoting traits and induction of plant defense enzymes to suppress soil-borne pathogens [27]. Qessaoui et al. [73] recently reported that Pseudomonas strain Q13B played an important role in plant growth promotion under greenhouse conditions by increasing plant length and collar diameter compared to control. In accordance with the previous studies, the results of the present study showed that P. fluorescens VSMKU3054 significantly suppressed the bacterial wilt incidence and further increased the shoot and root lengths of tomato plants. Furthermore, it could be used as a biofertilizer and biocontrol agent to replace alternative chemical pesticides, improve plant growth in tomato plants and inhibit soil-borne pathogens [3,48,74,75].
5. Conclusions
In conclusion, the present study suggests higher antagonistic activity of DAPG-producing P. fluorescens VSMKU3054 against R. solanacearum and plant growth-promoting activity. P. fluorescens VSMKU3054 has the ability to colonize plant systems and also might express superior biocontrol activity against tomato bacterial wilt disease in both in vitro and in vivo conditions. The study strongly recommends that P. fluorescens VSMKU3054 be used as a formulated biopesticide that substitutes for chemical pesticides and also reduces harmful effects on the environment.
Author Contributions
P.S. (Perumal Suresh): designed the study, investigation, writing manuscript and interpreting the results. M.R. and S.G.: helpful for improvement of the manuscript and validating the data. V.R.: manuscript review and editing. M.P.S. and M.V.A.: data analysis. P.S. (Perumal Sakthivel) and K.S.: compound purification and identification. V.S.: designed the study, supervision, validation, manuscript review and editing. All authors have read and agreed to the published version of the manuscript.
Funding
This research received no external funding.
Institutional Review Board Statement
Not applicable.
Informed Consent Statement
Not applicable.
Data Availability Statement
Not applicable.
Acknowledgments
The authors are greatly acknowledged the UGC-BSR Meritorious Fellowship, DST-PURSE, UGC NRCBS Program and RUSA-MKU (File No:011/RUSA/MKU/2020-2021) for the completion of this research work.
Conflicts of Interest
The authors declare that they have no conflict of interest.
References
- Jacobs, J.M.; Babujee, L.; Meng, F.; Milling, A.; Allen, C. The in planta transcriptome of Ralstonia solanacearum: Conserved physiological and virulence strategies during bacterial wilt of tomato. mBio 2012, 3, e00114-12. [Google Scholar] [CrossRef] [PubMed]
- Popoola, A.; Ganiyu, S.; Enikuomehin, O.; Bodunde, J.; Adedibu, O.; Durosomo, H.; Karunwi, O. Isolation and Characterization of Ralstonia solanacearum Causing Bacterial Wilt of Tomato in Nigeria. Niger. J. Biotechnol. 2015, 29, 1. [Google Scholar] [CrossRef][Green Version]
- Mohammed, A.F.; Oloyede, A.R.; Odeseye, A.O. Biological control of bacterial wilt of tomato caused by Ralstonia solanacearum using Pseudomonas species isolated from the rhizosphere of tomato plants. Arch. Phytopathol. Plant Prot. 2020, 53, 1–16. [Google Scholar] [CrossRef]
- Denny, T.P. Plant pathogenic Ralstonia species. In Plant-Associated Bacteria; Gnanamanickam, S.S., Ed.; Springer: Dordrecht, The Netherlands, 2007; pp. 573–644. [Google Scholar] [CrossRef]
- Cho, H.; Song, E.S.; Lee, Y.K.; Lee, S.; Lee, S.W.; Jo, A.; Lee, B.M.; Kim, J.G.; Hwang, I. Analysis of genetic and pathogenic diversity of Ralstonia solanacearum causing potato bacterial wilt in Korea. Plant Pathol. J. 2018, 34, 23–34. [Google Scholar] [CrossRef]
- Nguyen, M.T.; Ranamukhaarachchi, S.L. Soil-borne antagonists for biological control of bacterial wilt disease caused by Ralstonia solanacearum in tomato and pepper. J. Plant Pathol. 2010, 92, 395–406. [Google Scholar] [CrossRef]
- Aino, M. Studies on biological control of bacterial wilt caused by Ralstonia solanacearum using endophytic bacteria. J. Gen. Plant Pathol. 2016, 82, 323–325. [Google Scholar] [CrossRef]
- Alit-Susanta, W.G.N.; Takikawa, Y. Phenotypic characterization of Pseudomonas fluorescens PfG32R and its spontaneous gacS mutants and biocontrol activity against bacterial wilt disease of tomato. J. Gen. Plant Pathol. 2006, 72, 168–175. [Google Scholar] [CrossRef]
- Garrido-Sanz, D.; Arrebola, E.; Martínez-Granero, F.; García-Méndez, S.; Muriel, C.; Blanco-Romero, E.; Martín, M.; Rivilla, R.; Redondo-Nieto, M. Classification of isolates from the Pseudomonas fluorescens complex into phylogenomic groups based in group-specific markers. Front. Microbiol. 2017, 8, 1–10. [Google Scholar] [CrossRef]
- Ramamoorthy, V.; Viswanathan, R.; Raguchander, T.; Prakasam, V.; Samiyappan, R. Induction of systemic resistance by plant growth promoting rhizobacteria in crop plants against pests and diseases. Crop Prot. 2001, 20, 1–11. [Google Scholar] [CrossRef]
- Ramamoorthy, V.; Raguchander, T.; Samiyappan, R. Induction of defense-related proteins in tomato roots treated with Pseudomonas fluorescens Pf1 and Fusarium oxysporum f. sp. lycopersici. Plant Soil 2002, 239, 55–68. [Google Scholar] [CrossRef]
- Suresh, P.; Shanmugaiah, V.; Rajakrishnan, R.; Muthusamy, K.; Ramamoorthy, V. Pseudomonas fluorescens VSMKU3054 mediated induced systemic resistance in tomato against Ralstonia solanacearum. Physiol. Mol. Plant Pathol. 2022, 119, 101836. [Google Scholar] [CrossRef]
- Marimuthu, S.; Subbian, P.; Ramamoorthy, V.; Samiyappan, R. Synergistic effect of combined application of Azospirillum and Pseudomonas fluorescens with inorganic fertilizers on root rot incidence and yield of cotton. J. Plant Dis. Prot. 2002, 109, 569–577. [Google Scholar]
- Ramamoorthy, V.; Govindaraj, L.; Dhanasekaran, M.; Vetrivel, S.; Kumar, K.K.; Ebenezar, E. Combination of driselase and lysing enzyme in one molar potassium chloride is effective for the production of protoplasts from germinated conidia of Fusarium verticillioides. J. Microbiol. Methods 2015, 111, 127–134. [Google Scholar] [CrossRef] [PubMed]
- Arrebola, E.; Tienda, S.; Vida, C.; De Vicente, A.; Cazorla, F.M. Fitness features involved in the biocontrol interaction of Pseudomonas chlororaphis with host plants: The case study of PcPCL1606. Front. Microbiol. 2019, 10, 1–8. [Google Scholar] [CrossRef] [PubMed]
- Haas, D.; Keel, C.; Laville, J.; Maurhofer, M.; Oberhänsli, T.; Schnider, U.; Voisard, C.; Wüthrich, B.; Defago, G. Secondary metabolites of Pseudomonas fluorescens strain CHA0 involved in the suppression of root diseases. In Advances in Molecular Genetics of Plant-Microbe Interactions; Springer: Dordrecht, The Netherlands, 1991; Volume 1, pp. 450–456. [Google Scholar] [CrossRef]
- Scales, B.S.; Dickson, R.P.; Lipuma, J.J.; Huffnagle, G.B. Microbiology, genomics, and clinical significance of the Pseudomonas fluorescens species complex, an unappreciated colonizer of humans. Clin. Microbiol. Rev. 2014, 27, 927–948. [Google Scholar] [CrossRef]
- Moin, S.; Ali, S.A.; Hasan, K.A.; Tariq, A.; Sultana, V.; Ara, J.; Ehteshamul-Haque, S. Managing the root rot disease of sunflower with endophytic fluorescent Pseudomonas associated with healthy plants. Crop Prot. 2020, 130, 105066. [Google Scholar] [CrossRef]
- Keel, C.; Schnider, U.; Maurhofer, M.; Voisard, C.; Laville, J.; Burger, U.; Wirthner, P.J.; Haas, D.; Défago, G. Suppression of Root Diseases by Pseudomonas fluorescens CHA0: Importance of the Bacterial Secondary Metabolite 2,4-Diacetylphloroglucinol. Mol. Plant-Microbe Interact. 1992, 5, 4. [Google Scholar] [CrossRef]
- Almario, J.; Moënne-loccoz, Y.; Muller, D. Soil Biology & Biochemistry Monitoring of the relation between 2, 4-diacetylphloroglucinol-producing Pseudomonas and Thielaviopsis basicola populations by real-time PCR in tobacco black root-rot suppressive and conducive soils. Soil Biol. Biochem. 2013, 57, 144–155. [Google Scholar] [CrossRef]
- Zhou, T.T.; Li, C.Y.; Chen, D.; Wu, K.; Shen, Q.R.; Shen, B. PhlF- mutant of Pseudomonas fluorescens J2 improved 2,4-DAPG biosynthesis and biocontrol efficacy against tomato bacterial wilt. Biol. Control 2014, 78, 1–8. [Google Scholar] [CrossRef]
- Tada, M.; Takakuwa, T.; Nagai, M.; Yoshii, T. Antiviral and antimicrobial activity of 2, 4-Diacylphloroglucinols, 2-Acylcyclohexane-1, 3-diones and 2-Carboxamidocyclo-hexane-1, 3-diones. Agr. Biol. Chem. 1990, 54, 3061–3063. [Google Scholar] [CrossRef]
- Zhou, T.; Chen, D.; Li, C.; Sun, Q.; Li, L.; Liu, F.; Shen, Q.; Shen, B. Isolation and characterization of Pseudomonas brassicacearum J12 as an antagonist against Ralstonia solanacearum and identification of its antimicrobial components. Microbiol. Res. 2012, 167, 388–394. [Google Scholar] [CrossRef] [PubMed]
- Veena, V.K.; Kennedy, K.; Lakshmi, P.; Krishna, R.; Sakthivel, N. Anti-leukemic, anti-lung, and anti-breast cancer potential of the microbial polyketide 2, 4-diacetylphloroglucinol (DAPG) and its interaction with the metastatic proteins than the antiapoptotic Bcl-2 proteins. Mol. Cell. Biochem. 2016, 414, 47–56. [Google Scholar] [CrossRef] [PubMed]
- Ramesh, R.; Joshi, A.A.; Ghanekar, M.P. Pseudomonads: Major antagonistic endophytic bacteria to suppress bacterial wilt pathogen, Ralstonia solanacearum in the eggplant (Solanum melongena L.). World J. Microbiol. Biotechnol. 2009, 25, 47–55. [Google Scholar] [CrossRef]
- Chandrasekaran, M.; Subramanian, D.; Yoon, E.; Kwon, T.; Chun, S.C. Meta-analysis reveals that the genus Pseudomonas can be a better choice of biological control agent against bacterial wilt disease caused by Ralstonia solanacearum. Plant Pathol. J. 2016, 32, 216–227. [Google Scholar] [CrossRef] [PubMed]
- Elsayed, T.R.; Jacquiod, S.; Nour, E.H.; Sørensen, S.J.; Smalla, K. Biocontrol of Bacterial Wilt Disease Through Complex Interaction Between Tomato Plant, Antagonists, the Indigenous Rhizosphere Microbiota, and Ralstonia solanacearum. Front. Microbiol. 2020, 10, 1–15. [Google Scholar] [CrossRef]
- Kwak, Y.S.; Han, S.; Thomashow, L.S.; Rice, J.T.; Paulitz, T.C.; Kim, D.; Weller, D.M. Saccharomyces cerevisiae genome-wide mutant screen for sensitivity to 2, 4-diacetylphloroglucinol, an antibiotic produced by Pseudomonas fluorescens. Appl. Environ. Microbiol. 2011, 77, 1770–1776. [Google Scholar] [CrossRef]
- Suresh, P.; Varathraju, G.; Shanmugaiah, V.; Almaary, K.S.; Elbadawi, Y.B.; Mubarak, A. Partial purification and characterization of 2, 4-diacetylphloroglucinol producing Pseudomonas fluorescens VSMKU3054 against bacterial wilt disease of tomato. Saudi J. Biol. Sci. 2021, 28, 2155–2167. [Google Scholar] [CrossRef]
- Suresh, P.; Shanmugaiah, V.; Almaary, K.S.; Dawoud, T.M.; Elbadawi, Y.B. Fluorescent pseudomonads (FPs) as a potential biocontrol and plant growth promoting agent associated with tomato rhizosphere. J. King Saud Univ.-Sci. 2021, 33, 101423. [Google Scholar] [CrossRef]
- Naik, P.R.; Raman, G.; Narayanan, K.B.; Sakthivel, N. Assessment of genetic and functional diversity of phosphate solubilizing fluorescent pseudomonads isolated from rhizospheric soil. BMC Microbiol. 2008, 8, 1–14. [Google Scholar] [CrossRef]
- Shanmugaiah, V.; Mathivanan, N.; Balasubramanian, N.; Manoharan, P.T. Optimization of cultural conditions for production of chitinase by Bacillus laterosporous MML2270 isolated from rice rhizosphere soil. Afr. J. Biotechnol. 2008, 7, 2562–2568. [Google Scholar] [CrossRef]
- Alexander, D.B.; Zuberer, D.A. Use of chrome azurol S reagents to evaluate siderophore production by rhizosphere bacteria. Biol. Fertil. Soils 1991, 12, 39–45. [Google Scholar] [CrossRef]
- Bakker, A.W.; Schippers, B. Microbial cyanide production in the rhizosphere in relation to potato yield reduction and Pseudomonas SPP-mediated plant growth-stimulation. Soil Biol. Biochem. 1987, 19, 451–457. [Google Scholar] [CrossRef]
- Pikovskaya, R.I. Mobilization of phosphorus in soil in connection with vital activity of some microbial species. Mikrobiologiya. 1948, 17, 362–370. [Google Scholar]
- Harikrishnan, H.; Shanmugaiah, V.; Balasubramanian, N.; Sharma, M.P.; Kotchoni, S.O. Antagonistic potential of native strain Streptomyces aurantiogriseus VSMGT1014 against sheath blight of rice disease. World J. Microbiol. Biotechnol. 2014, 30, 3149–3161. [Google Scholar] [CrossRef] [PubMed]
- Immanuel, J.E.; Hemamalini, R.; Gnanamanickam, S.S. Genetic Diversity of Biocontrol Strains of Pseudomonas fluorescens Producing 2, 4-diacetylphloroglucinol from Southern India. J. Crop Improv. 2012, 26, 228–243. [Google Scholar] [CrossRef]
- Biniarz, P.; Coutte, F.; Gancel, F.; Łukaszewicz, M. High-throughput optimization of medium components and culture conditions for the efficient production of a lipopeptide pseudofactin by Pseudomonas fluorescens BD5. Microb. Cell Fact. 2018, 17, 121. [Google Scholar] [CrossRef]
- Paret, M.L.; Cabos, R.; Kratky, B.A.; Alvarez, A.M. Effect of plant essential oils on Ralstonia solanacearum race 4 and bacterial wilt of edible ginger. Plant Dis. 2010, 94, 521–527. [Google Scholar] [CrossRef]
- Yang, L.; Wu, L.; Yao, X.; Zhao, S.; Wang, J.; Li, S.; Ding, W. Hydroxycoumarins: New, effective plant-derived compounds reduce Ralstonia pseudosolanacearum populations and control tobacco bacterial wilt. Microbiol. Res. 2018, 215, 15–21. [Google Scholar] [CrossRef]
- Ramalingam, V.; Revathidevi, S.; Shanmuganayagam, T.; Muthulakshmi, L.; Rajaram, R. Biogenic gold nanoparticles induce cell cycle arrest through oxidative stress and sensitize mitochondrial membranes in A549 lung cancer cells. RSC Adv. 2016, 6, 20598–20608. [Google Scholar] [CrossRef]
- Cai, L.; Chen, J.; Liu, Z.; Wang, H.; Yang, H.; Ding, W. Magnesium oxide nanoparticles: Effective agricultural antibacterial agent against Ralstonia solanacearum. Front. Microbiol. 2018, 9, 1–19. [Google Scholar] [CrossRef]
- Xue, Q.Y.; Chen, Y.; Li, S.M.; Chen, L.F.; Ding, G.C.; Guo, D.W.; Guo, J.H. Evaluation of the strains of Acinetobacter and Enterobacter as potential biocontrol agents against Ralstonia wilt of tomato. Biol. Control 2009, 48, 252–258. [Google Scholar] [CrossRef]
- Amaresan, N.; Jayakumar, V.; Kumar, K.; Thajuddin, N. Biocontrol and plant growth-promoting ability of plant-associated bacteria from tomato (Lycopersicum esculentum) under field condition. Microb. Pathog. 2019, 136, 103713. [Google Scholar] [CrossRef] [PubMed]
- Tan, S.; Dong, Y.; Liao, H.; Huang, J.; Song, S.; Xu, Y.; Shen, Q. Antagonistic bacterium Bacillus amyloliquefaciens induces resistance and controls the bacterial wilt of tomato. Pest Manag. Sci. 2013, 69, 1245–1252. [Google Scholar] [CrossRef] [PubMed]
- Abo-Elyousr, K.A.M.; Khalil Bagy, H.M.M.; Hashem, M.; Alamri, S.A.M.; Mostafa, Y.S. Biological control of the tomato wilt caused by Clavibacter michiganensis subsp. michiganensis using formulated plant growth-promoting bacteria. Egypt. J. Biol. Pest Control 2019, 29. [Google Scholar] [CrossRef]
- Jayalakshmi, R.; Oviya, R.; Premalatha, K.; Mehetre, S.T.; Paramasivam, M.; Kannan, R.; Theradimani, M.; Pallavi, M.S.; Mukherjee, P.K.; Ramamoorthy, V. Production, stability and degradation of Trichoderma gliotoxin in growth medium, irrigation water and agricultural soil. Sci. Rep. 2021, 11, 16536. [Google Scholar] [CrossRef]
- Vanitha, S.C.; Niranjana, S.R.; Mortensen, C.N.; Umesha, S. Bacterial wilt of tomato in Karnataka and its management by Pseudomonas fluorescens. BioControl 2009, 54, 685–695. [Google Scholar] [CrossRef]
- Xue, Q.Y.; Ding, G.C.; Li, S.M.; Yang, Y.; Lan, C.Z.; Guo, J.H.; Smalla, K. Rhizocompetence and antagonistic activity towards genetically diverse Ralstonia solanacearum strains—An improved strategy for selecting biocontrol agents. Appl. Microbiol. Biotechnol. 2013, 97, 1361–1371. [Google Scholar] [CrossRef]
- Vidhyasekaran, P.; Kamala, N.; Ramanathan, A.; Rajappan, K.; Paranidharan, V.; Velazhahan, R. Induction of systemic resistance by Pseudomonas fluorescens Pf1 against Xanthomonas oryzae pv. Oryzae in rice leaves. Phytoparasitica 2001, 29, 155. [Google Scholar] [CrossRef]
- Cantore, P.L.O.; Shanmugaiah, V.; Nicola, S.I. Antibacterial activity of essential oil components and their potential use in seed disinfection. J. Agric. Food Chem. 2009, 57, 9454–9461. [Google Scholar] [CrossRef]
- Cabanás, C.G.L.; Legarda, G.; Ruano-Rosa, D.; Pizarro-Tobías, P.; Valverde-Corredor, A.; Niqui, J.L.; Triviño, J.C.; Roca, A.; Mercado-Blanco, J. Indigenous Pseudomonas spp. Strains from the Olive (Olea europaea L.) rhizosphere as effective biocontrol agents against Verticillium dahliae: From the host roots to the bacterial genomes. Front. Microbiol. 2018, 9. [Google Scholar] [CrossRef]
- Chenniappan, C.; Narayanasamy, M.; Daniel, G.M.; Ramaraj, G.B.; Ponnusamy, P.; Sekar, J.; Vaiyapuri Ramalingam, P. Biocontrol efficiency of native plant growth promoting rhizobacteria against rhizome rot disease of turmeric. Biol. Control 2019, 129, 55–64. [Google Scholar] [CrossRef]
- Costa, R.; Gomes, N.C.; Peixoto, R.S.; Rumjanek, N.; Berg, G.; Mendonça-Hagler, L.C.; Smalla, K. Diversity and antagonistic potential of Pseudomonas spp. associated to the rhizosphere of maize grown in a subtropical organic farm. Soil Biol. Biochem. 2006, 38, 2434–2447. [Google Scholar] [CrossRef]
- Alsohim, A.S.; Taylor, T.B.; Barrett, G.A.; Gallie, J.; Zhang, X.X.; Altamirano-Junqueira, A.E.; Johnson, L.J.; Rainey, P.B.; Jackson, R.W. The biosurfactant viscosin produced by Pseudomonas fluorescens SBW 25 aids spreading motility and plant growth promotion. Environ. Microbiol. 2014, 16, 2267–2281. [Google Scholar] [CrossRef] [PubMed]
- Rai, R.; Srinivasamurthy, R.; Dash, P.K.; Gupta, P. Isolation, characterization and evaluation of the biocontrol potential of Pseudomonas protegens RS-9 against Ralstonia solanacearum in Tomato. Indian J. Exp. Biol. 2017, 55, 595–603. [Google Scholar]
- Vinay, J.U.; Naik, M.K.; Rangeshwaran, R.; Chennappa, G.; Shaikh, S.S.; Sayyed, R.Z. Detection of antimicrobial traits in fluorescent pseudomonads and molecular characterization of an antibiotic pyoluteorin. 3 Biotech 2016, 6, 1–11. [Google Scholar] [CrossRef]
- Durairaj, K.; Velmurugan, P.; Park, J.H.; Chang, W.S.; Park, Y.J.; Senthilkumar, P.; Choi, K.M.; Lee, J.H.; Oh, B.T. Potential for plant biocontrol activity of isolated Pseudomonas aeruginosa and Bacillus stratosphericus strains against bacterial pathogens acting through both induced plant resistance and direct antagonism. FEMS Microbiol. Lett. 2017, 364, 1–8. [Google Scholar] [CrossRef]
- Shanahan, P.; O’Sullivan, D.J.; Simpson, P.; Glennon, J.D.; O’Gara, F. Isolation of 2,4-diacetylphloroglucinol from a fluorescent pseudomonad and investigation of physiological parameters influencing its production. Appl. Environ. Microbiol. 1992, 58, 353–358. [Google Scholar] [CrossRef]
- Harikrishnan, H.; Shanmugaiah, V.; Nithya, K.; Balasubramanian, N.; Sharma, M.P.; Gachomo, E.W.; Kotchoni, S.O. Enhanced production of phenazine-like metabolite produced by Streptomyces aurantiogriseus VSMGT1014 against rice pathogen, Rhizoctonia solani. J. Basic Microbiol. 2016, 56, 153–161. [Google Scholar] [CrossRef]
- Schmidt, N.G.; Żądło-Dobrowolska, A.; Ruppert, V.; Höflehner, C.; Wiltschi, B.; Kroutil, W. Molecular cloning, expression, and characterization of acyltransferase from Pseudomonas protegens. Appl. Microbiol. Biotechnol. 2018, 102, 6057–6068. [Google Scholar] [CrossRef]
- Saber, F.M.A.; Abdelhafez, A.A.; Hassan, E.A.; Ramadan, E.M. Characterization of fluorescent pseudomonads isolates and their efficiency on the growth promotion of tomato plant. Ann. Agric. Sci. 2015, 60, 131–140. [Google Scholar] [CrossRef]
- Sekar, J.; Prabavathy, V.R. Novel Phl-producing genotypes of finger millet rhizosphere associated pseudomonads and assessment of their functional and genetic diversity. FEMS Microbiol. Ecol. 2014, 89, 32–46. [Google Scholar] [CrossRef] [PubMed]
- Ayyadurai, N.; Ravindra Naik, P.; Sreehari Rao, M.; Sunish Kumar, R.; Samrat, S.K.; Manohar, M.; Sakthivel, N. Isolation and characterization of a novel banana rhizosphere bacterium as fungal antagonist and microbial adjuvant in micropropagation of banana. J. Appl. Microbiol. 2006, 100, 926–937. [Google Scholar] [CrossRef] [PubMed]
- Brucker, R.M.; Baylor, C.M.; Walters, R.L.; Lauer, A.; Harris, R.N.; Minbiole, K.P.C. The identification of 2,4-diacetylphloroglucinol as an antifungal metabolite produced by cutaneous bacteria of the salamander plethodon cinereus. J. Chem. Ecol. 2008, 34, 39–43. [Google Scholar] [CrossRef] [PubMed]
- Marchand, P.A.; Weller, D.M.; Bonsall, R.F. Convenient Synthesis of 2, 4-Diacetylphloroglucinol, a Natural Antibiotic Involved in the Control of Take-All Disease of Wheat. J. Agric. Food Chem. 2000, 48, 1882–1887. [Google Scholar] [CrossRef]
- Gutiérrez-García, K.; Neira-González, A.; Pérez-Gutiérrez, R.M.; Granados-Ramírez, G.; Zarraga, R.; Wrobel, K.; Barona-Gómez, F.; Flores-Cotera, L.B. Phylogenomics of 2,4-Diacetylphloroglucinol-Producing Pseudomonas and Novel Antiglycation Endophytes from Piper auritum. J. Nat. Prod. 2017, 80, 1955–1963. [Google Scholar] [CrossRef]
- Kang, B.R. Biocontrol of tomato Fusarium wilt by a novel genotype of 2,4-diacetylphloroglucinol- producing Pseudomonas sp. NJ134. Plant Pathol. J. 2012, 28, 93–100. [Google Scholar] [CrossRef]
- Nagendran, S.; Vaikuntavasan, P.; Muthusamy, K.; Dananjeyan, B.; Venkatasamy, B. Chromatographic Detection of Antibacterial Antibiotics from Pseudomonas fluorescens (TNAU PF1) and Their Effect on Bacterial Wilt Pathogen Ralstonia solanacearum (KK2). Int. Res. J. Pure Appl. Chem. 2019, 20, 1–10. [Google Scholar] [CrossRef]
- Applerot, G.; Lellouche, J.; Lipovsky, A.; Nitzan, Y.; Lubart, R.; Gedanken, A.; Banin, E. Understanding the antibacterial mechanism of CuO nanoparticles: Revealing the route of induced oxidative stress. Small 2012, 8, 3326–3337. [Google Scholar] [CrossRef]
- Le Ouay, B.; Stellacci, F. Antibacterial activity of silver nanoparticles: A surface science insight. Nano Today 2015, 10, 339–354. [Google Scholar] [CrossRef]
- Roy, A.; Bulut, O.; Some, S.; Mandal, A.K.; Yilmaz, M.D. Green synthesis of silver nanoparticles: Biomolecule-nanoparticle organizations targeting antimicrobial activity. RSC Adv. 2019, 9, 2673–2702. [Google Scholar] [CrossRef]
- Qessaoui, R.; Bouharroud, R.; Furze, J.N.; El Aalaoui, M.; Akroud, H.; Amarraque, A.; Vaerenbergh, J.V.; Tahzima, R.; Mayad, E.H.; Chebli, B. Applications of New Rhizobacteria Pseudomonas Isolates in Agroecology via Fundamental Processes Complementing Plant Growth. Sci. Rep. 2019, 9, 12832. [Google Scholar] [CrossRef] [PubMed]
- Ge, X.; Wei, W.; Li, G.; Sun, M.; Li, H.; Wu, J.; Hu, F. Isolated Pseudomonas aeruginosa strain VIH2 and antagonistic properties against Ralstonia solanacearum. Microb. Pathog. 2017, 111, 519–526. [Google Scholar] [CrossRef] [PubMed]
- Shanmugaiah, V.; Ramesh, S.; Jayaprakashvel, M.; Mathivanan, N. Biocontrol and plant growth promoting potential of a Pseudomonas sp. MML2212 from the rice rhizosphere. Mitt Biol. Bundesanst Land Forstwirtsch 2006, 408, 320–324. [Google Scholar]
Publisher’s Note: MDPI stays neutral with regard to jurisdictional claims in published maps and institutional affiliations. |
© 2022 by the authors. Licensee MDPI, Basel, Switzerland. This article is an open access article distributed under the terms and conditions of the Creative Commons Attribution (CC BY) license (https://creativecommons.org/licenses/by/4.0/).